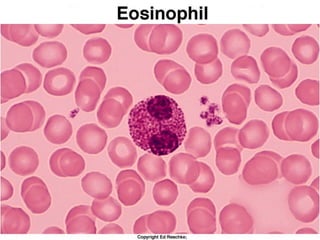

The document summarizes key concepts about blood, including:
1. Blood is composed of plasma, red blood cells, white blood cells, and platelets. Red blood cells carry oxygen, while white blood cells help fight infection.
2. The production and lifespan of red blood cells is described, along with the different types of white blood cells. Hemostasis and blood clotting are explained briefly.
3. Blood typing is discussed, including the ABO and Rh blood group systems. Compatibility for blood transfusions depends on the presence or absence of antigens on red blood cells.